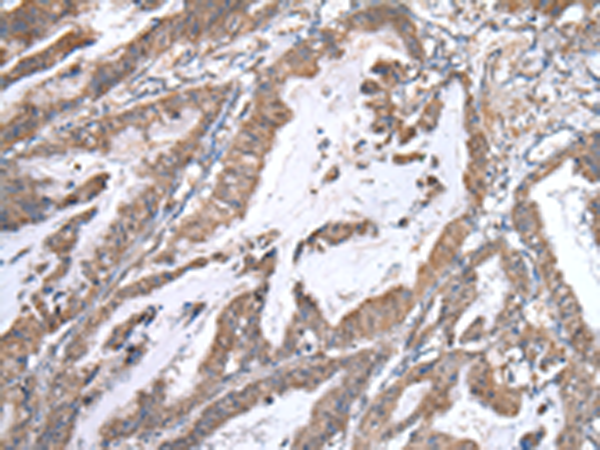
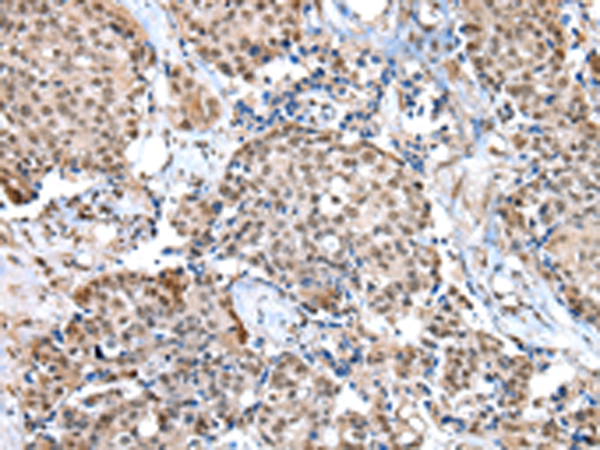
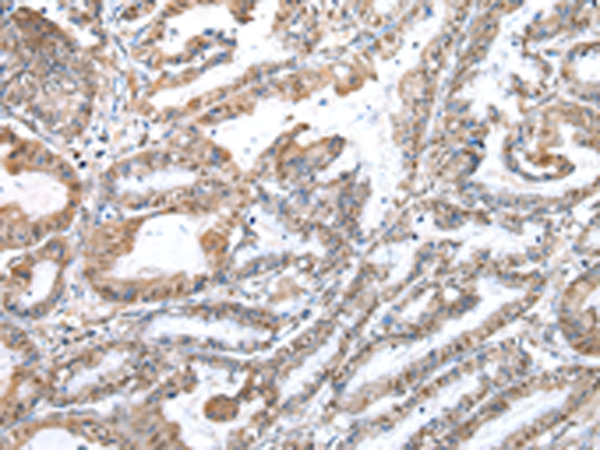

-
分类: 科研抗体货号: P09026别名: CG1I; ZNFN4A1应用: WB,IHC反应种属: Human, Mouse
-
分类: 科研抗体货号: P09005别名: AIP5; Tiul1; hSDRP1应用: WB,IHC反应种属: Human, Mouse
-
分类: 科研抗体货号: P08989别名: SWD3; BIG-3; CFAP89应用: WB,IHC反应种属: Human, Mouse, Rat
-
分类: 科研抗体货号: P09025别名: BCA2; ZNF364应用: IHC反应种属: Human, Mouse
-
分类: 科研抗体货号: P09004别名: SWIP1; WSB-1应用: WB反应种属: Human, Mouse
-
分类: 科研抗体货号: P08988别名: TRM82; TRMT82应用: WB,IHC反应种属: Human, Mouse
-
分类: 科研抗体货号: P09024别名: HOF; DPZF; PRIMS; ODA-8S; ZNF288应用: IHC反应种属: Human, Mouse
-
分类: 科研抗体货号: P09016别名: mkr5应用: WB反应种属: Human
-
分类: 科研抗体货号: P09003别名: NG7; DIR1; FKBP4; WISP39应用: IHC反应种属: Human, Mouse, Rat
-
分类: 科研抗体货号: P09023别名: HZF3应用: IHC反应种属: Human

鄂公网安备42018502007531号
鄂公网安备42018502007531号

